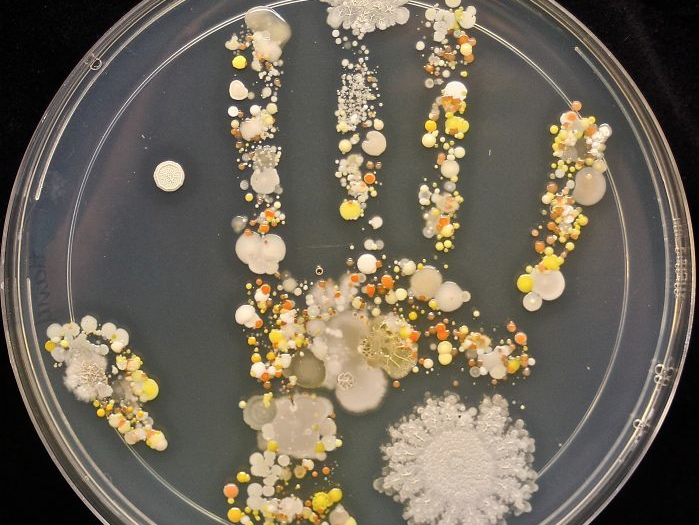

10 foto che rivelano il lato nascosto delle cose
21 Marzo 2019
La vita di tutti i giorni ci porta a non prestare attenzione alle cose belle della natura. E meno che mai al suo lato invisibile, nascosto. Cosa c’è dietro la pelliccia di un leone? Come sono fatti i cristalli di sale se li guardiamo al microscopio? Quello che crediamo vero a volte non lo è: dietro si cela un mondo fantastico tutto da scoprire!
Sfoglia la gallery per vedere 10 foto che mostrano il lato nascosto della natura… quello che non hai mai visto prima!
(Credits photo: Boredpanda)